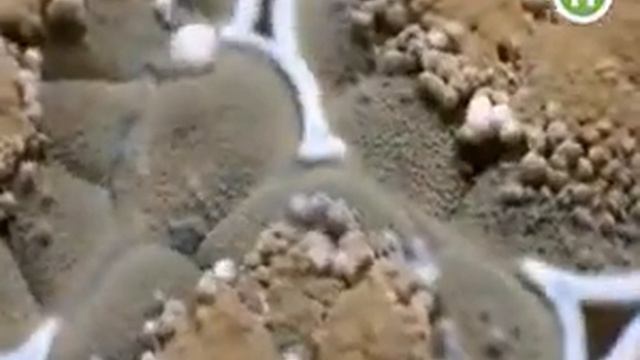
Плесень смотреть онлайн

Автор / Канал: Чистка с улыбкой Страница 5

Замена ступицы - ступичного подшипника (крайслер 300с, додж, мерседес)

Шмерлинг Д.С. НИС "Методы сбора и анализа социологической информации", 16.03.2022

Гель для удаления пыли с клавиатуры компьютера,салона автомобиля.Распаковка,обзор посылки из Китая

Про систему EGR на дизельних двигунах. А саме 2.0 hdi

Как быстро очистить сковороду от нагара и жира

Три САМЫЕ Урожайные ПОМИДОРЫ 2022 года!

Fada Кераміка - Чистка кухонної раковини

Самсунг А51. Чехол 360 силикон, защитное стекло и пленка 3D на обратную сторону.

13 times James Stewart left everyone SPEECHLESS

Оригинальный радиатор АКПП для Mitsubishi Lancer по цене обычного

Чем Больше, тем Лучше и СЕРДЦЕ КРЕПЧЕ - 5 продуктов для СОСУДОВ и ДОЛГОЛЕТИЯ

УСТАНОВКА ЦПГ, РАЗБОРКА и СБОРКА ГОЛОВКИ на Атланте

Отключение MAT сенсора BMW

План - закон, выполнение - долг, перевыполнение - честь!

игра стирать всё подряд

мойка Толеро TGR-860 -черная. Нержавейка со стеклом.

Дислалия

Доработка поршней на Юпитер

Epson L110 Waste Ink Pad Cleaning and Maintenance | Printer with ipis at bubuyog

Кондиционер Hyundai HSH P 091 NDC

ЕГЭ по информатике СТРИМ #1

Full Scan and Update Kaspersky Endpoint Security 11
Плесень

Nº1 de Chanel Powder-to-Foam Cleanser
За каждым успешным каналом стоит личность, идея и сотни часов кропотливого труда. Если вы здесь, значит, автор «Чистка с улыбкой» уже сумел зацепить ваше внимание своим уникальным стилем или подачей. А мы на RUVIDEO позаботились о том, чтобы вы могли изучить весь архив его работ в максимально комфортных условиях — без лишней суеты и преград.
Почему за работами канала «Чистка с улыбкой» так интересно наблюдать? Всё просто: это честный контент, который находит отклик в сердцах зрителей. На нашем ресурсе вы можете смотреть онлайн все видео любимого автора бесплатно и в хорошем качестве. Нам важно, чтобы вы видели каждую деталь и слышали каждый нюанс, поэтому мы используем только стабильные плееры из открытых источников Rutube.
Следите за новинками канала, пересматривайте старые шедевры и открывайте для себя новые грани творчества «Чистка с улыбкой». Мы постоянно обновляем ленту, чтобы у вас под рукой всегда были самые свежие выпуски. Никаких сложных регистраций — только вы и творчество, которое вдохновляет. Приятного вам путешествия по миру авторского контента на RUVIDEO!
Видео взято из открытых источников Rutube. Если вы правообладатель, обратитесь к первоисточнику.